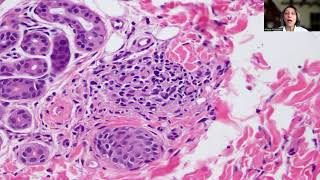

Skin Biopsy Interpretation Dr Dharitri Bhatt, GMC Nagpur video
Online izle ve mp4 mp3 formatlarinda yukle

Videonun muddeti: 33:06
Skin Biopsy Interpretation Dr Dharitri Bhatt, GMC Nagpur videosu mp4 ve mp3 yuklemek ucun hazirdir
Diqqet! Siz Mp4 yukle ve ya Mp3 yukle duymesine basdiqdan sonra eger sistem sizi reklam sehifesine atarsa o zaman derhal geri qayidib emeliyyati tekrar edin ve faylin yuklemek ucun hazir olmasini gozleyin
Videodan Mp4 Yukle
Videodan Mp3 Yukle-1
Videodan Mp3 Yukle-2
Oxshar Axtarishlar
 Skin Biopsy Interpretation Dr Dharitri Bhatt, GMC Nagpur
Skin Biopsy Interpretation Dr Dharitri Bhatt, GMC Nagpur Skin Biopsy 💉🧏♀️ Procedure By Dermatologist || Dr. Priyanka Reddy || DNA Skin Clinic || #shorts
Skin Biopsy 💉🧏♀️ Procedure By Dermatologist || Dr. Priyanka Reddy || DNA Skin Clinic || #shorts Skin Biopsy Interpretation Dr Dharitri Bhatt, GMC Nagpur
Skin Biopsy Interpretation Dr Dharitri Bhatt, GMC Nagpur Approach to skin lesions on biopsy - A pattern based approach
Approach to skin lesions on biopsy - A pattern based approach Skin Biopsy #shorts #biopsy #skin #chennai #diagnosis #cells
Skin Biopsy #shorts #biopsy #skin #chennai #diagnosis #cells Derm performs skin cancer testing! #skincancer #mole #dermreacts
Derm performs skin cancer testing! #skincancer #mole #dermreacts Tip-26; Interpretation of Skin Biopsies
Tip-26; Interpretation of Skin Biopsies How a biopsy for cancer diagnosis is done | With help of potato | Dr. Gaurav Gangwani
How a biopsy for cancer diagnosis is done | With help of potato | Dr. Gaurav Gangwani Punch Biopsy: A Comprehensive Guide to Understanding the Procedure
Punch Biopsy: A Comprehensive Guide to Understanding the Procedure
Video Mp4 Mp3Azwap.Biz
Azwap.Biz 2021-2023


 Skin Biopsy Interpretation Dr Dharitri Bhatt, GMC Nagpur
Skin Biopsy Interpretation Dr Dharitri Bhatt, GMC Nagpur Skin Biopsy 💉🧏♀️ Procedure By Dermatologist || Dr. Priyanka Reddy || DNA Skin Clinic || #shorts
Skin Biopsy 💉🧏♀️ Procedure By Dermatologist || Dr. Priyanka Reddy || DNA Skin Clinic || #shorts Skin Biopsy Interpretation Dr Dharitri Bhatt, GMC Nagpur
Skin Biopsy Interpretation Dr Dharitri Bhatt, GMC Nagpur Approach to skin lesions on biopsy - A pattern based approach
Approach to skin lesions on biopsy - A pattern based approach Skin Biopsy #shorts #biopsy #skin #chennai #diagnosis #cells
Skin Biopsy #shorts #biopsy #skin #chennai #diagnosis #cells Derm performs skin cancer testing! #skincancer #mole #dermreacts
Derm performs skin cancer testing! #skincancer #mole #dermreacts Tip-26; Interpretation of Skin Biopsies
Tip-26; Interpretation of Skin Biopsies How a biopsy for cancer diagnosis is done | With help of potato | Dr. Gaurav Gangwani
How a biopsy for cancer diagnosis is done | With help of potato | Dr. Gaurav Gangwani Punch Biopsy: A Comprehensive Guide to Understanding the Procedure
Punch Biopsy: A Comprehensive Guide to Understanding the Procedure